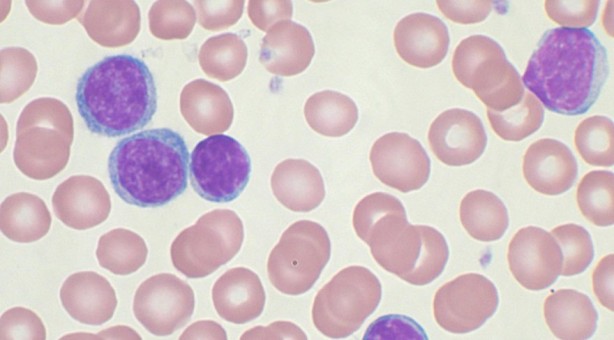
Avrupa ülkesinde çığır açacak buluş! Milyonlarca insana umut verdi

Avrupa ülkesinde çığır açacak buluş! Milyonlarca insana umut verdi
Alman bilim insanları tarafından yapılan yeni bir çalışma, felçli farelere tekrar yürüme yeteneği kazandırdı ve dünya çapında felç geçiren yaklaşık 5,4 milyon insana umut verdi. Bochum Ruhr Üniversitesi’nden araştırmacıları sinir hücrelerinin birbirleriyle iletişimini sağlayan sitokin proteinlerini genetik olarak yeniden kodlayarak, farelerin hasar görmüş omurilik sistemini uyarmayı başardı. Belden aşağısı felçli olan hayvanlar tedaviden iki ile üç hafta sonra yürümeye başladı.